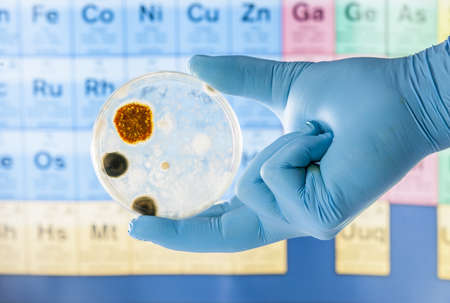
Mold growing in a Petri dish being held with gloveの写真素材

写真素材 - Mold growing in a Petri dish being held with glove
キーワード
- air
- analysis
- assistant
- bacterium
- biology
- biotechnology
- chemical
- chemist
- chemistry
- colony
- culture
- danger
- disease
- environmental
- epidemic
- experiment
- fungi
- germs
- grow
- growth
- hand
- health
- hygiene
- influenza
- lab
- laboratory
- medical
- medicine
- microbiology
- microorganism
- mold
- mould
- pandemic
- petri
- petri dish
- pharmacy
- plate
- research
- sample
- science
- scientific
- sickness
- specimen
- spores
- substance
- technology
- test
- virus
- work
- dish
類似作品
A vibrant ecosy...
photo of fungi ...
white mold grow...
Empty slide abo...
Colony characte...
A top-down macr...
photo of fungi ...
Mold Beautiful,...
Diverse microor...
Molds colonies ...
A vibrant and c...
Backgrounds of ...
Characteristics...
Backgrounds of ...
A top-down view...
A fascinating m...
Backgrounds of ...
Mixed of bacter...
mold in orange ...
development of ...
Backgrounds of ...
Close up of Asp...
bone marrow sam...
agar plates wit...
Penicillium, as...
Close up of Asp...
Penicillium, as...
Penicillium, as...
macro of green ...
close-up of bac...
petri dish with...
Petri dish with...
A detailed view...
moldy yogurt, g...
Penicillium, as...
photo of fungi ...
Penicillium, as...
closeup of big ...
spread of green...
Mold Beautiful,...
Colony characte...
Molds colonies ...
A close-up view...
Backgrounds of ...
blue mold on st...
Mold samples on...
Backgrounds of ...
fungi on agar p...
A dirty plate c...